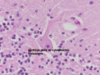

Neuro Flashcards
(81 cards)
What is the organization of the meninges in the spinal cord?

What structure in the ventricles of the brain produces CSF?
choroid plexus
Blood-brain barrier structure

The arrows are pointing to what?

activated microglia
Cell Type

Gitter cells (aka microglia ingesting myelin- foamy cytoplasm)

chromatolysis
Alive or dead neuron?

dead

neuronophagia

spheroid
Steps of wallerian degeneration

Why can regeneration of neurons occur in the PNS but not in the CNS?

Cell type

Reactive astrocytes

gemistocytic astrocytes
Cell type and commonly associate dz

Alzheimer’s type II astrocytes: enlarged, vesicular nuclei; hepatic encephalopathy

microglial nodules
VIRAL infections
premature degradation of normally formed tissues?
abiotrophy
What type of CNS malformation is shown?

hydrocephalus
What type of CNS malformation is shown?

hydrocephalus
What type of CNS malformation is shown?

microencephaly
A lhaso apso presents with this

Lissencephaly

Prosencephalic hypoplasia

Prosencephalic hypoplasia

Cranium bifidum

Cranium bifidum
Meningoencephalocele